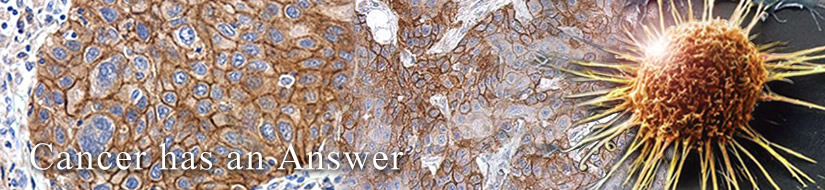
Oncoproteins

![]() |
The products of metazoan cell proto-oncogenes are generally key constituents of the cell signaling and gene expression machinery that regulate cell growth and proliferation. When mutated, amplified, or otherwise expressed in a dysregulated manner, these genes can become cellular oncogenes and their oncoprotein products drive tumorigenic cell growth. Examples of proto-oncogenes include the RAS genes, ERBB2, MYC, and ABL1. Certain viruses, or oncoviruses, have the capability to cause cancers through the action of viral genome-encoded oncoproteins that target metazoan cell factors or pathways.
|
|
|
|
||||||||||||||||
|
|
|
|
||||||||||||||||
|
||||
![AKT antibody [N3C2], Internal](/upload/media/research/Cancer/Oncogenes/Oncoproteins_01.jpg)



![EGFR antibody [N1-2], N-term](/upload/media/research/Cancer/Oncogenes/Oncoproteins_05.jpg)

![Her2 / ErbB2 antibody [C2C3], C-term](/upload/media/research/Cancer/Oncogenes/Oncoproteins_07.jpg)

